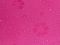

Dámský skládací deštník kouzelný 1 pudrová, 1 ks
Dámský skládací deštník kouzelný
Vyberte variantu:
1 pudrová, 1 ks
Vyberte si požadovanou variantu produktu.
Jestli je u varianty zobrazena barva, je to pouze barva ilustrativní a nemusí se přesně shodovat s barvou zboží.
Jestli je u varianty zobrazena barva, je to pouze barva ilustrativní a nemusí se přesně shodovat s barvou zboží.
| Kód | Název | s DPH | Dostupnost | |
|---|---|---|---|---|
| ST530002 | 1 pudrová, 1 ks | 251,91 Kč | Skladem | |
| ST530002 | 2 růžová malinová, 1 ks | 251,91 Kč | Skladem | |
| ST530002 | 3 zelená sv., 1 ks | 251,91 Kč | Skladem | |
| ST530002 | 5 modrá azuro, 1 ks | 251,91 Kč | Skladem | |
| ST530002 | 7 tyrkys sv., 1 ks | 251,91 Kč | Skladem |
Hodnocení (0x)Ještě nikdo nehodnotil.
Varianty
Informace o zboží Dámský skládací deštník kouzelný 1 pudrová, 1 ks
Dámský skládací deštník s unikátním efektem! Trik spočívá v tom, že když je deštník suchý, má jednobarevný potah. Při kontaktu s vodou se na potahu jako kouzlem objeví nádherný květinový vzor. Deštník je skladný, pohodlně se vejde do kabelky. Obstojí i v silném větru, pružné lamely zajišťují vysokou pevnost a stabilitu.
UV filtr vás ochrání před slunečním zářením. Rukojeť deštníku je plastová, opatřená poutkem. Konstrukce deštníku se skládá z osmi polí. Součástí deštníku je ochranný obal.
Hloubka deštníku je 18 cm.
Celková délka je 65 cm.
Délka složeného deštníku je 24 cm.
- Rukojeť: plastová
- Průměr: 96 cm
- Délka: 24 cm
- Hmotnost: 264 g
- Manuální, UV filtr
Materiál: kov, polyester, plast
Výrobce/distributor: Stoklasa textilní galanterie s.r.o., Průmyslová 934/13, 747 23 Bolatice
Vaše recenze
Podělte se o své zkušenosti s produktem Dámský skládací deštník kouzelný 1 pudrová, 1 ks s ostatními návštěvníky.
Buďte první, kdo přidá svůj názor.